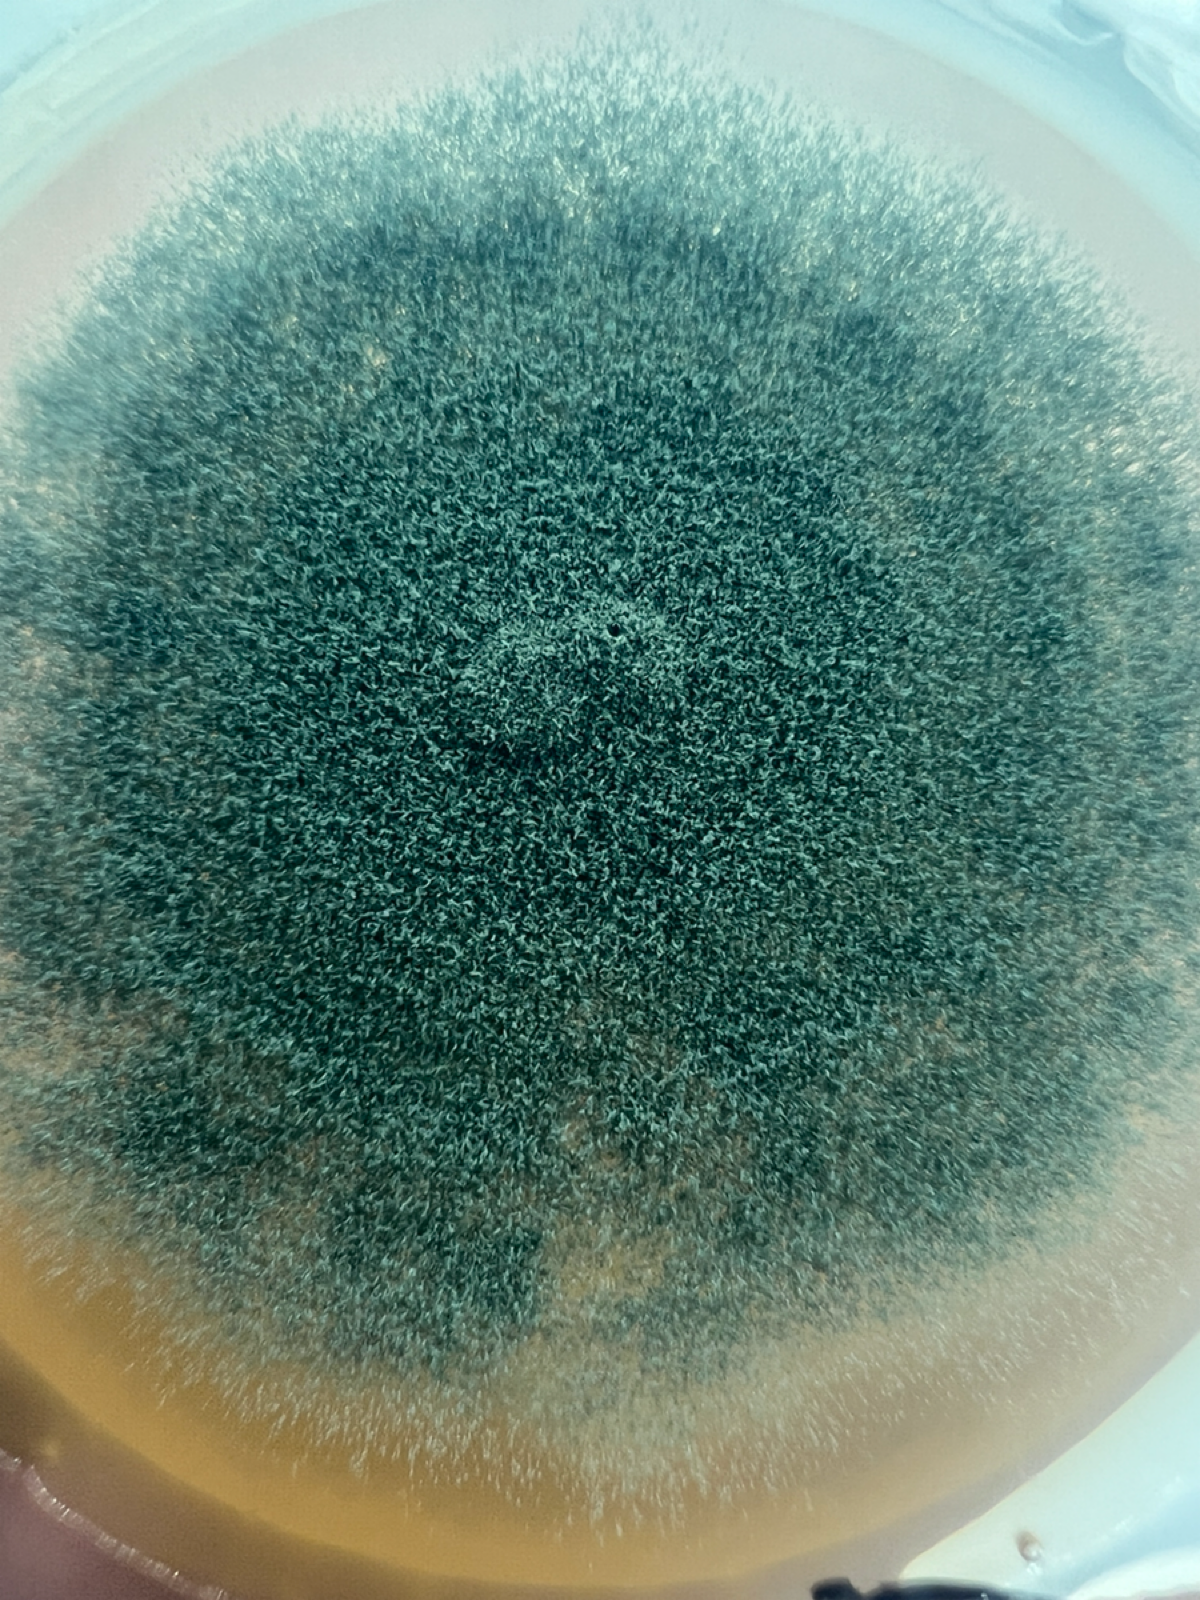
Апдейт по грибам | Сетка — социальная сеть от hh.ru

Апдейт по грибам
Во-первых, плесень на сыре начала расти. Через несколько дней буду прокалывать его спицей, чтобы создать комфортные места для дальнейшего разрастания
Во-вторых, провел эксперимент со средой на основе экстракта солода, вместо мёда. Получилось гораздо лучше. Среда получилась дешевой. Не стал покупать лабораторные препараты. Взял экстракт солода для пивоварения и обычный агар-агар 900 bloom вместо микробиологического. В эксперименте принимали участие 3 концентрации агара и 3 солода. Всего 9 вариантов, каждого по 10 банок. Хорошо было для оценки результатов собрать все споры и взвесить их, но это слишком трудозатратно. Я оценивал только визуально пушистость и площадь покрытия. Присваивал 1 тем банкам, которые мне нравятся и 0 тем, что не нравятся и потом выбрал группу, набравшую больше всего баллов. Оценка слабая, но базовое приближение дает. У меня победил вариант, с агаром 12 г/л и экстрактом солода 30 г/л.